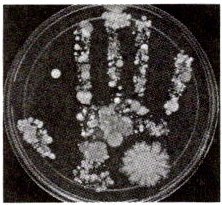

5. 为检测自来水中是否有细菌和真菌,下列实验操作不正确的是(
A.在没有实施实验前,不能打开培养皿
B.设计一个空白实验,用来检验培养基高温灭菌是否彻底
C.接种时,要注意无菌操作
D.接种后,两套培养皿放在不同的环境中培养
D
)A.在没有实施实验前,不能打开培养皿
B.设计一个空白实验,用来检验培养基高温灭菌是否彻底
C.接种时,要注意无菌操作
D.接种后,两套培养皿放在不同的环境中培养
答案:
D
6. (绥化中考)霉菌是一种微生物。下列最容易滋生霉菌的是(
A.干燥的衣物
B.密封的罐头
C.潮湿的粮食
D.真空包装的食品
C
)A.干燥的衣物
B.密封的罐头
C.潮湿的粮食
D.真空包装的食品
答案:
C
7. 新考向证据推理(贵阳期末)破伤风杆菌感染人体后会使人患破伤风。当伤口较深时(如被铁钉扎伤)容易得破伤风,而皮肤表面被划破一般不会得破伤风,这说明破伤风杆菌的生存不需要(
A.氧气
B.水
C.有机物
D.适宜的温度
A
)A.氧气
B.水
C.有机物
D.适宜的温度
答案:
A
8. 人们常说“菌从手来,病从口入”,人手上通常分布着大量微生物。如图所示为无菌固体培养基经人手按压并培养一段时间后菌落生长的结果,下列相关叙述不正确的是(

A.该培养基适合放在37℃恒温环境中培养
B.手上可能既有细菌又有真菌
C.细菌、真菌在自然界中广泛分布
D.用清水洗手可起到灭菌作用
D
)
A.该培养基适合放在37℃恒温环境中培养
B.手上可能既有细菌又有真菌
C.细菌、真菌在自然界中广泛分布
D.用清水洗手可起到灭菌作用
答案:
D
9. 科学思维分析(焦作模拟)用培养液培养三种细菌,让它们在三支不同的试管中生长,如图显示了细菌的生长层。如果此时往三支试管中通入氧气,则细菌的繁殖速度可能发生的变化是(


B
)

答案:
B 【解析】由图示分析可知:第Ⅰ种细菌处于试管底部,属于厌氧细菌;第Ⅱ种细菌与培养液相融合,属于兼性细菌;第Ⅲ种细菌处于培养液上部,与空气相通,属于好氧细菌。如果此时往三支试管中通入氧气,第Ⅰ种是厌氧细菌,其生长受到抑制;第Ⅱ种没有发生变化;第Ⅲ种是好氧细菌,繁殖速度加快。
10. 核心素养探究实践许多同学在思考问题时,有咬笔杆的习惯。为了帮助这些同学改掉这一不良习惯,生物兴趣小组设计了一个实验,探究“笔杆上是否有细菌和真菌”。实验方案如下:

(1)本实验的变量是
(2)步骤①将所有实验器具和培养基进行
(3)步骤②中,A、B两组分别设置了三个组别,目的是
(4)步骤③相当于培养细菌和真菌的一般方法中的
(5)实验中观察到的现象:A组培养基上均有许多大小不同的菌落,B组培养基上均无菌落。据此得出结论:
(6)新考法开放性试题根据实验结论,你想对同学们说:
(1)本实验的变量是
有无细菌和真菌
;设置B组实验是为了作对照
。(2)步骤①将所有实验器具和培养基进行
高温灭菌
,目的是防止杂菌干扰实验
。(3)步骤②中,A、B两组分别设置了三个组别,目的是
避免偶然性,减小实验误差
。(4)步骤③相当于培养细菌和真菌的一般方法中的
接种
步骤。(5)实验中观察到的现象:A组培养基上均有许多大小不同的菌落,B组培养基上均无菌落。据此得出结论:
笔杆上有细菌和真菌
。(6)新考法开放性试题根据实验结论,你想对同学们说:
咬笔杆是不卫生的行为(合理即可)
。
答案:
(1)有无细菌和真菌 作对照
(2)高温灭菌 防止杂菌干扰实验
(3)避免偶然性,减小实验误差
(4)接种
(5)笔杆上有细菌和真菌
(6)咬笔杆是不卫生的行为(合理即可)
(1)有无细菌和真菌 作对照
(2)高温灭菌 防止杂菌干扰实验
(3)避免偶然性,减小实验误差
(4)接种
(5)笔杆上有细菌和真菌
(6)咬笔杆是不卫生的行为(合理即可)
查看更多完整答案,请扫码查看


